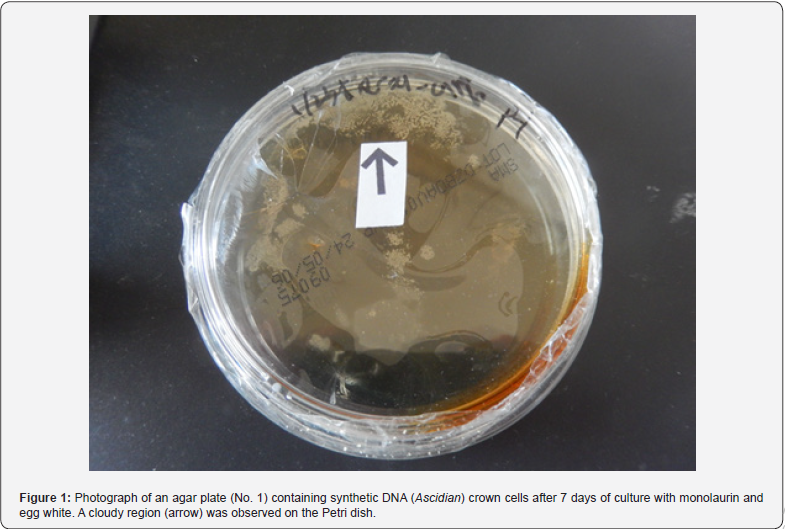
Click here to view Large Figure 1
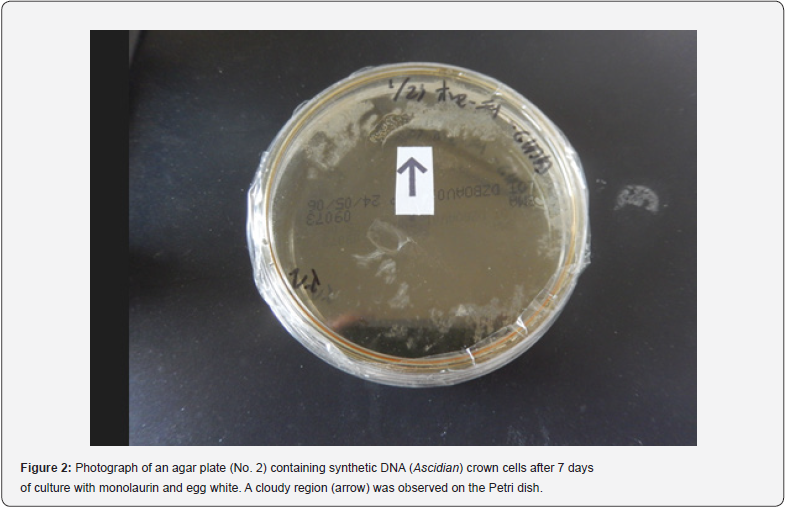
Click here to view Large Figure 2

Morning glory- and Dandelion-like Objects Created in Agar Cultures of Synthetic DNA (Ascidian) Crown Cells with Monolaurin and Egg white
Shoshi Inooka*
Japan Association of Science Specialists, Japan
Submission: March 22, 2024; Published: April 02, 2024
*Corresponding author: Shoshi Inooka, Japan Association of Science Specialists, Japan
How to cite this article: Shoshi Inooka*. Morning glory- and Dandelion-like Objects Created in Agar Cultures of Synthetic DNA (Ascidian) Crown Cells with Monolaurin and Egg white. Ann Rev Resear. 2024; 10(5): 555800. DOI: 10.19080/ARR.2024.10.555800
Abstract
Synthesized DNA crown cells (synthetic cells), capable of proliferating in egg white in vivo, can be prepared using sphingosine (Sph)-DNA-adenosine-monolaurin. Synthesized DNA crown cells form assemblies and proliferate in the presence of monolaurin and egg white, as well as in cultures on agar plates. In previous experiments on synthetic DNA (E. coli/Human placenta) crown cells, the proliferation of objects similar in appearance to thalli or double cells was observed in cultures on agar plates. In the present experiments using synthetic DNA (Ascidian) crown cells and egg white, various objects and cell proliferation were observed on agar plates. Here, the appearance of morning glory- and dandelion-like objects that proliferated in cultures are introduced and their microscopic characteristics are described.
Keywords: Synthetic DNA (Ascidian) crown cells; Agar plate cultures; Sphingosine-DNA; Cells; Objects like morning glory; Monolaurin; Egg white
Abbreviations: A-M: Adenosine-monolaurin; SMA: Standard agar medium; sph: Sphingosine
Introduction
Artificial cells that are covered with DNA are referred to as DNA crown cells [1-3]. Synthetic DNA crown cells can develop into DNA crown cells after culture in egg white and can be prepared using sphingosine (Sph)-DNA and adenosine-monolaurin (A-M) compounds. Such DNA crown cells formed assemblies or cells that proliferated in cultures with monolaurin [4-6] and could be cultivated in test tubes [7-10]. In addition, assembly formation and cell proliferation has been observed in cultures on agar plates [11,12]. In previous studies, various types of cell proliferation were microscopically observed when monolaurin-treated synthetic DNA (E. coli/Human placenta) crown cells were cultivated with or without egg white on agar plates [13,16]. The present experiments examined whether such objects were observed when synthetic DNA (Ascidian) crown cells were cultured with egg white and monolaurin on agar plates. Numerous kinds of objects and cell proliferation patterns were observed. Here, the appearance of morning glory- and dandelion-like objects that proliferated in cultures are introduced and their microscopic characteristics are described.
Materials and Methods
Materials
The materials used were the same as those employed in previous studies [14,15]: Sph (Tokyo Kasei, Japan), DNA (obtained from edible ascidian sea squirts), adenosine (Sigma-Aldrich; Wako, Japan), monolaurin (Tokyo Kasei), and adenosine-monolaurin (A-M), a compound synthesized from a mixture of adenosine and monolaurin [14,15]. Monolaurin solutions were prepared to a final concentration of 0.1 M in distilled water. Agar plates, using standard agar medium (SMA) (AS ONE, Japan) were used. Egg whites and edible ascidian sea squirts were obtained from a local market.
Methods
Preparation of synthetic DNA (Ascidian sea squirt) crown cells: Synthetic DNA (Ascidian) crown cells were prepared as described previously [14,15]. Briefly, 180 μL of Sph (10 mM) and 50 μL of DNA (0.05μg/μL) were combined, and the mixture was heated and cooled twice. A-M solution (100 μL) was added, and the mixture was incubated at 37°C for 15 min. Next, 30 μL of monolaurin solution was added and the mixture was incubated at 37°C for another 5 min. The resulting suspension was used as the synthetic DNA (Ascidian) crown cells.
Culture of monolaurin with DNA (Ascidian) crown cells and incubation with egg white on agar plates was performed as follows:
i. A total of 50.0 μL of sample was plated on two agar plates with a bacteria spreader.
ii. Immediately, 1.5 mL of twice diluted 0.1 M monolaurin was poured onto each agar plate.
iii. After removing excess monolaurin, the plates were inverted and incubated for 3 h at 37°C.
iv. Then, 1.5 mL of egg white was poured onto the plate and excess egg white was removed.
v. The plates were inverted and incubated for 7 days at 37°C and observed at 5 and 7 days.
vi. After 7 days of incubation, the plates were stored at 4°C.
Microscopic observations
Objects on plates were observed directly under a light microscope and with the naked eye.
Results and Discussion
Figure 1 shows a photograph of an agar plate (No. 1) containing synthetic DNA (Ascidian) crown cells after 7 days of culture with monolaurin and egg white. A cloudy region (arrow), visible with the naked eye, is clearly observed in the Petri dish. The diameter of the Petri dish is 8.0 cm. Figure 2 shows a photograph of another agar plate (No. 2) containing synthetic DNA (Ascidian) crown cells after 7 days of culture with monolaurin and egg white. A cloudy region (arrow), visible with the naked eye, is clearly observed in the Petri dish. The diameter of the Petri dish is 8.0 cm. Figure 3 shows the microscopic appearance of synthetic DNA (Ascidian) crown cells shown in Figure 1 after 5 days of culture in egg white. Morning glory-like objects measuring approximately 50–60 μm are observed (arrow a). Figure 4 shows the microscopic appearance of synthetic DNA (Ascidian) crown cells shown in Figure 1 after 5 days of culture in egg white. Morning glory-like objects of different sizes are observed (arrows a and b). Also, elongated flattened barlike objects are observed (arrow c). Objects with rugged surfaces measuring approximately 50–60 μm are observed (arrow d). Figure 5 shows the microscopic appearance of synthetic DNA (Ascidian) crown cells shown in Figure 2 after 7 days of culture in egg white. Objects similar in appearance to dandelions that measure approximately 50–60 μm (arrow b) are also observed (arrows a and b). Figure 6 shows the microscopic appearance of synthetic DNA (Ascidian) crown cells shown in Figure 2 after 7 days of culture in egg white. Objects similar in appearance to dandelions of various sizes are observed (arrows a, b, and c). In addition elongated flattened bar-like objects (arrow d) are observed. The measure 8 arrow b) is approximately 20–25 μm.

In previous experiments using synthetic DNA (E. coli/Human placenta) crown cell, objects similar in appearance to Thalus or double cells were observed on agar plates [13,16]. The present experiments examined whether similar objects were observed in agar cultures of synthetic DNA (Ascidian) crown cells in the presence of monolaurin and egg white. Numerous morning glorylike objects were observed (Figure 3, arrow a). These objects appeared to consist of three structures (marble-like objects on the outside, green objects in the middle, and yellow objects on the inside). However, color may not be a useful distinguishing feature, as it can change depending on the observation conditions used for microscopy. Numerous morning glory-like objects (Figure 4, arrow a) were observed together with large objects of various shapes (Figure 4, arrows c and d). The identity of the large objects is unclear (Figure 4, arrows c and d); however, they may be assemblies that consist of Sph/DNA: adenosine-monolaurin and components of egg white. The morning glory-like object may have born from these elongated flatted bar-like large objects (Figure 4, arrow c).

In addition, numerous morning glory-like objects were observed within objects with ragged edges (Figure 4, arrow d), suggesting that morning glory-like objects also proliferated from these objects with ragged edges (Figure 4, arrow d). Objects similar in appearance to dandelions were observed (Figure 5, arrows a and b). These objects may be derived from objects that appeared like bunches of feathers. Although the formation mechanisms of the dandelion-like objects are unclear, they may be explained based on Figure 5. Three objects similar in appearance to dandelions were observed (Figure 5, arrows a, b, and c). Objects (arrow c) may be derived from other objects (Figure 5, arrow d) to form an extended layer. As shown in Figure 4, elongated flattened bar like objects (arrow d) may be a kind of assembly and consist of Sph-DNA-adenosine-monolaurin and components of egg white. Therefore, objects like dandelions, which may be derived from the elongated flattened bar like object (arrow d) may be composed of Sph-DNA, adenosine-monolaurin, and egg white components. Large spaces could be observed with the naked eye (Figure 1 & Figure 2) and numerous objects and/or features of cell proliferation could be observed within the spaces.

The two kinds of objects, morning glory- and dandelion-like objects, were observed within a limited space and observations were limited. These objects are only described here because their features are very characteristic. Similarly, objects with characteristic features were observed in synthetic DNA (E. coli) and (Human placenta) crown cells, but in synthetic DNA (Ascidian) crown cells, objects were observed that have not been observed in previous crown cells. These findings suggest that objects particular to DNA, which was used in the preparation of synthetic DNA (Ascidian) crown cells, may have been formed. On the other hand, although the present objects appeared to be alive based on the naked-eye observation that the objects grew in the Petri dishes (Figure 1 and 2), further evidence is required to confirm that these objects were living. Consequently, more experimental evidence is required to clarify whether the above objects are formed in other kinds of synthetic DNA crown cells, i.e., in addition to synthetic DNA (E. coli/Human placenta/Ascidian) crown cells. Regarding the nomenclature of these objects, those that have the appearance of a morning glory are named Protochordata (Ascidian) SDCCME (MG), and objects that have the appearance of a dandelion are named Protochordata (Ascidian) SDCCME (Dan). Ascidian (Origin of DNA source), where SDCC refers to synthetic DNA crown cells, ME refers to monolaurin and egg white, MG refers to morning glory, and Dan refers to dandelion.
References
- Inooka S (2012) Preparation and cultivation of artificial cells. App Cell Biol 25: 13-18.
- Inooka S (2016) Preparation of Artificial Cells Using Eggs with Sphingosine-DNA. J Chem Eng Process Technol 7(1): 277.
- Inooka S (2016) Aggregation of sphingosine-DNA and cell construction using components from egg white. Integrative Molecular Medicine 3(6): 1-5.
- Inooka S (2021) Microscopic observation of assemblies formed in mixtures of DNA (Human placenta) crown cells with Bacilus subtilius. An archive of organic and inorganic science 5(2).
- Inooka S (2020) Assembly Formation of Synthetic DNA ( coli) crown cells with Salt. Reconstruction and Regeneration of Synthetic DNA Crown Cells. American Journal of Biomedical Science p. 16.
- Inooka S (2022) Cell Proliferation from the Assembly of Synthetic DNA ( coli) Crown Cells with Stimulation by Monolaurin Twice. Current Trends in Biotechnology & Microbiology 2(5).
- Inooka S (2022) Preparation of a DNA ( coli) Crown Cell line in Vitro-Microscopic Appearance of Cells. Annals of Reviews and Research 2022.8(1) ARR.MS.ID.555728.
- Inooka S (2023) Preparation and Microscopic Appearance of a DNA (Human Placenta) Crown Cell Line. Journal of Biotechnology & Bioresearch 5(1).
- Inooka S (2023) Preparation of a DNA (Akoya pearl oyster) crown cell line. Applied Cell Biology Japan.
- Inooka S (2023) Preparation of a DNA (HepG2 is a hepatoblastorma-derived cell line) Crown Cell Line. Journal of Tumor Medicine & Prevention 4(2).
- Inooka S (2024) Microscopic appearance of Cell Assembly and Proliferation in Agar Cultures of Synthetic DNA ( coli) Crown Cells with Monolaurin. Chemical & Pharmaceutical Research 6(1): 1-4.
- Inooka S (2024) Microscopic Apperaarance of Monolaurin-Treated Syntheticc DNA ( coli) Crown Cells in Agar Medium Supplemented with Egg White. Scientic Journal Biology & Life Science 3(3): 2024.
- Inooka S (2024) Synthesis and Microscopic Appearance of Thalus-like Objects tin Synthetic DNA ( coli) Crown Cells Cretaed Using Monolaurin and Egg white. Open Access Journal of Reproductive System and Sexual Disorder 3(2).
- Inooka S (2017) Biotechnical and Systematic Preparation of Artificial Cells. The Global Journal of Research in Engineering 7(1).
- Inooka S (2017) Systenmatic Preparation of Artificail Cells (DNA Crown Cells). J Chem Eng Process Technol (8): 327.
- Inooka S (2024) Double Cell-Like Objects Created from Synthetic DNA (Human Placenta) Crown Cells Using Monolaurin. American Journal of Medical and Clinical Sciences 5(2): (1-3).

















